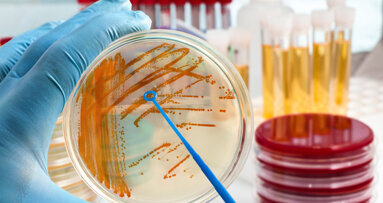
Studie: Zusammenhang von Zahnbehandlungen und Endokarditis

L'AQUILA, Italien – Italienische Forscher haben jüngst herausgefunden, dass sich eine vorhandene Parodontitis auf den Blutdruck auswirkt.
So haben Patienten mit einer Parodontitis einen höheren Blutdruck als mundgesunde Patienten. Zudem sprechen Hypertoniemedikamente schlechter an, wenn das Zahnbett entzündet ist.
Laut den Wissenschaftlern der Universität L’Aquila in Italien neigen Patienten mit 20-prozentiger Wahrscheinlichkeit zu Hypertonie, wenn eine Parodontitis diagnostiziert wurde. Gleichzeitig wirken Medikamente gegen zu hohen Blutdruck schlechter. Die Forscher empfehlen deshalb eine regelmäßige Blutdruckkontrolle bei Parodontitispatienten. Außerdem sollen Kardiologen ihre Hypertoniepatienten zum Zahnarzt überweisen, um eine Parodontitis auszuschließen bzw. behandeln zu lassen.
Für die Studie wurden Daten von 3.600 Personen ausgewertet, die unter Hypertonie leiden. Teilnehmer, bei denen keine Parodontitis nachweisbar war, hatten im Vergleich bessere Blutdruckwerte, zudem sprachen sie besser auf die Behandlung mit Hypertoniemedikamenten an. Wurde eine Parodontitis diagnostiziert, waren die Blutdruckwerte höher und die Behandlung mit Medikamenten schwieriger.
Den genauen Zusammenhang zwischen Parodontitis und Hypertonie haben die Forscher im Rahmen ihrer Studie, die in der Publikation Hypertension der American Heart Association veröffentlicht wurde, nicht klären können. Sie sehen ihre Forschungsergebnisse allerdings als Bestätigung früherer Studien, die bereits Zusammenhänge zwischen Parodontitis und Arteriosklerose sowie kardiovaskulären Erkrankungsrisiken nachweisen konnten.
Schlagwörter:
KÖLN – Eine Entzündung des Zahnhalteapparats (Parodontitis) hat möglicherweise etwas mit schwerem Asthma zu tun. Ob die Entzündung im Mund Folge oder ...
China – Karies zählt weltweit zu den häufigsten chronischen Erkrankungen und ihre Ursachen werden zunehmend vielschichtiger verstanden. Eine aktuelle ...
Sydney – Kopfschmerzen und saubere Zähne, das scheint auf den ersten Blick wenig zusammenzuhängen. Doch eine aktuelle Studie der Universität Sydney ...
PARIS, Frankreich – Forscher untersuchten den Zusammenhang von invasiven zahnmedizinischen Maßnahmen, Antibiotikaprophylaxe und durch orale Streptokokken...
OKAYAMA, Japan – Bruxismus verursacht aufgrund der stark einwirkenden Kräfte der Kiefermuskulatur nicht nur Schmerzen und Verspannungen, die ...
GREIFSWALD – Zahnmediziner der Universitätsmedizin Greifswald veröffentlichen neue Erkenntnisse im englischen Fachjournal.
Columbia – Ein Forscherteam aus den USA hat in einer groß angelegten Langzeitstudie Hinweise darauf gefunden, dass Parodontitis nicht nur das Zahnfleisch...
LEIPZIG – Eine kürzlich durchgeführte Studie konnte eine Verbindung zwischen atopischer Dermatitis (AD) und Abnormalitäten in der Zahnentwicklung, wie ...
PHILADELPHIA, USA – Bisherige Studien konnten einen Zusammenhang zwischen der Zusammensetzung der Darmflora und potenzieller Dickleibigkeit aufdecken.
HAMBURG – Frauen in der ärztlichen und psychotherapeutischen Versorgung bekommen im Schnitt weniger gute und sehr gute Bewertungen als männliche ...
Live-Webinar
Di. 23. Juni 2026
2:00 Uhr CET (Berlin)
Live-Webinar
Di. 23. Juni 2026
19:00 Uhr CET (Berlin)
Live-Webinar
Di. 23. Juni 2026
21:00 Uhr CET (Berlin)
Live-Webinar
Mi. 24. Juni 2026
14:00 Uhr CET (Berlin)
Live-Webinar
Mi. 24. Juni 2026
17:00 Uhr CET (Berlin)
Live-Webinar
Mi. 24. Juni 2026
18:30 Uhr CET (Berlin)
Dr. med. dent. Britta Hahn
Live-Webinar
Do. 25. Juni 2026
20:00 Uhr CET (Berlin)
Dr. Hatem Algraffee, Cat Edney



 Österreich / Österreich
Österreich / Österreich
 Bosnien und Herzegowina / Босна и Херцеговина
Bosnien und Herzegowina / Босна и Херцеговина
 Bulgarien / България
Bulgarien / България
 Kroatien / Hrvatska
Kroatien / Hrvatska
 Tschechien & Slowakei / Česká republika & Slovensko
Tschechien & Slowakei / Česká republika & Slovensko
 Frankreich / France
Frankreich / France
 Deutschland / Deutschland
Deutschland / Deutschland
 Griechenland / ΕΛΛΑΔΑ
Griechenland / ΕΛΛΑΔΑ
 Ungarn / Hungary
Ungarn / Hungary
 Italien / Italia
Italien / Italia
 Niederlande / Nederland
Niederlande / Nederland
 Nordic / Nordic
Nordic / Nordic
 Polen / Polska
Polen / Polska
 Portugal / Portugal
Portugal / Portugal
 Rumänien & Moldawien / România & Moldova
Rumänien & Moldawien / România & Moldova
 Slowenien / Slovenija
Slowenien / Slovenija
 Serbien & Montenegro / Србија и Црна Гора
Serbien & Montenegro / Србија и Црна Гора
 Spanien / España
Spanien / España
 Schweiz / Schweiz
Schweiz / Schweiz
 Türkei / Türkiye
Türkei / Türkiye
 Großbritannien und Irland / UK & Ireland
Großbritannien und Irland / UK & Ireland
 International / International
International / International
 Brasilien / Brasil
Brasilien / Brasil
 Kanada / Canada
Kanada / Canada
 Lateinamerika / Latinoamérica
Lateinamerika / Latinoamérica
 USA / USA
USA / USA
 China / 中国
China / 中国
 Indien / भारत गणराज्य
Indien / भारत गणराज्य
 Pakistan / Pākistān
Pakistan / Pākistān
 Vietnam / Việt Nam
Vietnam / Việt Nam
 ASEAN / ASEAN
ASEAN / ASEAN
 Israel / מְדִינַת יִשְׂרָאֵל
Israel / מְדִינַת יִשְׂרָאֵל
 Algerien, Marokko und Tunesien / الجزائر والمغرب وتونس
Algerien, Marokko und Tunesien / الجزائر والمغرب وتونس
 Naher Osten / Middle East
Naher Osten / Middle East